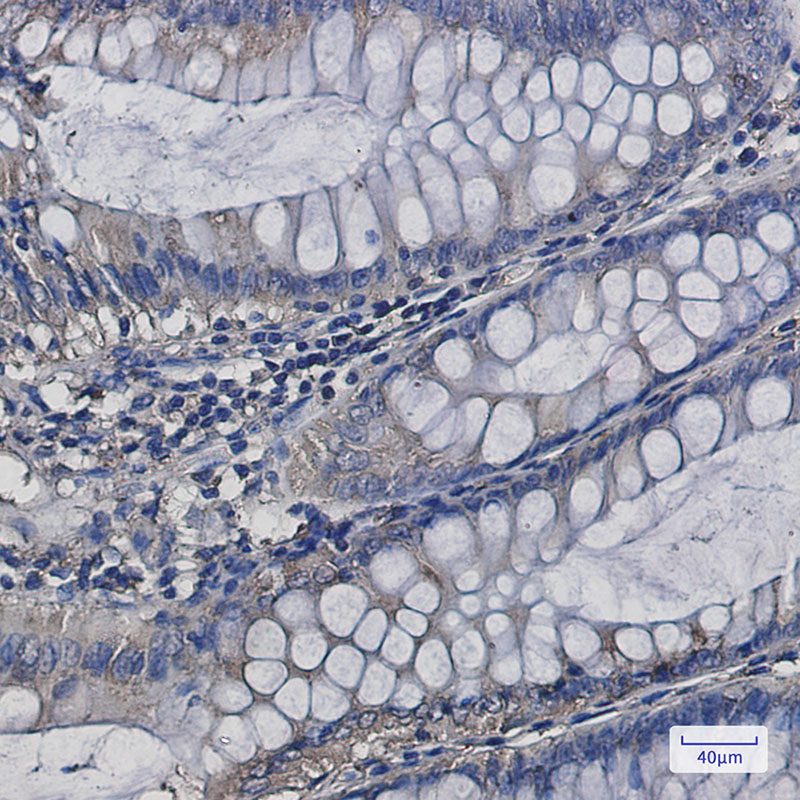

-
分类: 科研抗体货号: P21981别名: NET40; C9orf126应用: WB,IHC,IF反应种属: Human,Mouse,Rat
-
分类: 科研抗体货号: P21980别名: Protein PR264; Splicing component; 35 kDa; Splicing factor SC35; SC-35; Splicing factor; arginine/serine-rich 2应用: WB,IP,IHC反应种属: Human,Rat
-
分类: 科研抗体货号: P21996别名: HI95; SES2; SEST2应用: WB,IP,IF反应种属: Human,Mouse,Rat
-
分类: 科研抗体货号: P21979别名: Actin binding protein; Actinin alpha 2; ACTN2; Alpha actinin 2; CMD1AA应用: WB,IP,IHC反应种属: Human,Mouse,Rat
-
分类: 科研抗体货号: P22014别名: NTB-A; SLAMF6; Ly108; NK-T-B-antigen; CD352; KALI应用: WB,IP,IF反应种属: Human
-
分类: 科研抗体货号: P21995别名: ATP2A2; ATP2B; Sarcoplasmic/endoplasmic reticulum calcium ATPase 2; SERCA2; SR Ca(2+)-ATPase 2; Calcium pump 2; Calcium-transporting ATPase sarcoplasmic reticulum type; slow twitch skeletal muscle isoform; Endoplasmic reticulum class 1/2 Ca(2+) ATPase应用: WB,IHC,IF反应种属: Human,Rat
-
分类: 科研抗体货号: P21978别名: SAM domain-containing protein 9应用: WB,IF反应种属: Human
-
分类: 科研抗体货号: P22013别名: SKP1; EMC19; OCP2; SKP1A; TCEB1L; S-phase kinase-associated protein 1; Cyclin-A/CDK2-associated protein p19; Organ of Corti protein 2; OCP-2; Organ of Corti protein II; OCP-II; RNA polymerase II elongation factor-like protein; SIII; Transcr应用: WB,IF反应种属: Human,Mouse,Rat
-
分类: 科研抗体货号: P21994别名: septin 7; CDC3; CDC10; SEPT7; SEPT7A; NBLA02942应用: WB,IF反应种属: Human,Mouse,Rat
-
分类: 科研抗体货号: P21977别名: Zinc finger protein 797; Zinc finger protein SALL4应用: WB,IHC反应种属: Human

鄂公网安备42018502007531号
鄂公网安备42018502007531号

